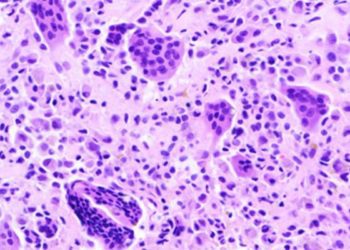

Adaptimmune’s Afami-cel is the first FDA-approved T-cell receptor therapy for synovial sarcoma
Afami-cel (Tecelra) is the first genetically engineered T-cell receptor therapy for synovial sarcoma Afami-cel demonstrated an overall response rate of ...